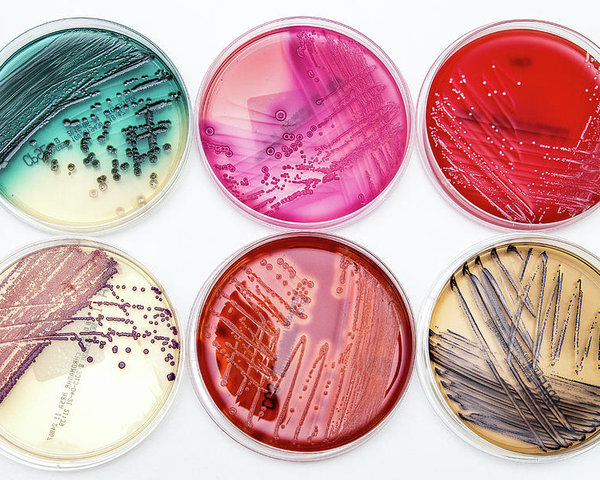

Os meios de cultura representam uma pedra angular no campo da microbiologia, sendo ferramentas indispensáveis para o isolamento, cultivo, identificação e estudo de microrganismos em ambiente laboratorial. Desde as suas primeiras formulações rudimentares até as sofisticadas preparações atuais, a evolução dos meios de cultura tem acompanhado e impulsionado os avanços científicos, permitindo uma compreensão cada vez mais profunda do universo microscópico. A capacidade de cultivar microrganismos fora de seus habitats naturais abriu portas para o diagnóstico de doenças infecciosas, o desenvolvimento de fármacos, a produção de alimentos e bebidas fermentadas, o controle de qualidade industrial e inúmeras outras aplicações que impactam diretamente a saúde humana, o meio ambiente e a biotecnologia. Este texto propõe uma jornada pela história dos meios de cultura, explorando sua descoberta, os marcos evolutivos cruciais e a diversidade de suas utilizações nos laboratórios contemporâneos, demonstrando como essa tecnologia fundamental continua a ser vital para a ciência e a indústria.
A Descoberta e os Primeiros Passos no Cultivo Microbiológico
A história da microbiologia e, consequentemente, dos meios de cultura, está intrinsecamente ligada à curiosidade humana sobre o mundo invisível. Embora os microrganismos tenham sido observados pela primeira vez no século XVII por Antonie van Leeuwenhoek com seus microscópios rudimentares, a capacidade de cultivá-los de forma controlada em laboratório só começou a se concretizar séculos depois. O marco inicial na utilização de meios de cultura é frequentemente atribuído a Louis Pasteur, por volta de 1860. Pasteur, em seus famosos experimentos para refutar a teoria da geração espontânea e investigar a fermentação, utilizou caldos nutritivos simples, como infusões de levedura, açúcar e sais de amônio, para demonstrar que os microrganismos não surgiam espontaneamente, mas sim a partir de outros microrganismos preexistentes e que necessitavam de um ambiente nutritivo para proliferar. Esses primeiros meios eram líquidos e apresentavam desafios significativos, como a dificuldade em isolar colônias puras e a sua instabilidade, especialmente em temperaturas mais elevadas, quando tendiam a se liquefazer.
A necessidade de um agente solidificante que permitisse o crescimento de colônias isoladas em uma superfície estável era premente. Inicialmente, a gelatina foi empregada para esse fim. No entanto, a gelatina possuía limitações consideráveis: liquefazia-se a temperaturas próximas a 23-25°C, que são ideais para o crescimento de muitos microrganismos, e, além disso, podia ser hidrolisada (digerida) por diversas bactérias, comprometendo a integridade do meio. A solução para esse impasse surgiu de uma fonte inesperada e graças à observação e engenhosidade de Fanny Hesse, esposa de Walther Hesse, um colega de Robert Koch. Por volta de 1881, Walther Hesse enfrentava os mesmos problemas com a liquefação dos meios de cultura à base de gelatina em seu laboratório. Fanny Hesse, que utilizava ágar-ágar – um polissacarídeo extraído de algas marinhas vermelhas – para preparar geleias e pudins que não derretiam mesmo em dias quentes, sugeriu a seu marido que experimentasse o ágar como agente solidificante para os meios de cultura. A sugestão provou-se revolucionária. O ágar-ágar solidificava a temperaturas mais altas (cerca de 40-45°C), permanecia sólido à temperatura de incubação da maioria das bactérias patogênicas (37°C), não era digerido pela maioria dos microrganismos e era translúcido, permitindo a visualização clara das colônias. Essa inovação, aparentemente simples, transformou radicalmente as práticas microbiológicas, possibilitando o isolamento de culturas puras e o estudo detalhado de microrganismos específicos.
Evolução e Marcos Históricos na Solidificação e Diversificação dos Meios
A introdução do ágar-ágar como agente solidificante foi um divisor de águas, mas a evolução dos meios de cultura não parou por aí. Outro desenvolvimento crucial foi a invenção da placa de Petri por Julius Richard Petri, assistente de Robert Koch, em 1887. Essa placa rasa e circular, com uma tampa que se encaixava frouxamente, permitia o fácil manuseio dos meios sólidos, a semeadura de amostras, a observação do crescimento colonial e a manutenção da esterilidade, minimizando a contaminação por microrganismos do ar. A combinação do ágar com a placa de Petri estabeleceu a base para as técnicas de isolamento e contagem de microrganismos que são utilizadas até hoje.
Com a capacidade de obter culturas puras, a pesquisa microbiológica floresceu. Cientistas começaram a desenvolver formulações de meios cada vez mais específicas para atender às necessidades nutricionais variadas dos diferentes microrganismos. Robert Koch, por exemplo, utilizou meios à base de batata e soro para isolar o bacilo da tuberculose (Mycobacterium tuberculosis) em 1882. A coloração de Gram, desenvolvida por Hans Christian Gram em 1884, embora não seja um meio de cultura, tornou-se uma ferramenta complementar essencial, permitindo a diferenciação rápida de bactérias com base na estrutura de suas paredes celulares e orientando a escolha de meios de cultura apropriados.
Ao longo do século XX, a diversidade de meios de cultura expandiu-se enormemente. Foram desenvolvidos meios para o cultivo de microrganismos fastidiosos (aqueles com exigências nutricionais complexas), anaeróbios (que crescem na ausência de oxigênio), fungos, vírus (que requerem células vivas para replicação, levando ao desenvolvimento de culturas celulares) e outros grupos específicos. A compreensão da fisiologia microbiana levou à criação de meios com composições definidas (sintéticos), onde todos os componentes químicos são conhecidos, e meios complexos (não sintéticos), que contêm ingredientes como extratos de carne, levedura ou peptona, cuja composição exata não é totalmente conhecida, mas que fornecem uma rica variedade de nutrientes.
Tipos de Meios de Cultura e Suas Aplicações Atuais
Atualmente, os laboratórios dispõem de uma vasta gama de meios de cultura, classificados de acordo com sua consistência (líquidos, sólidos, semissólidos) e, mais importante, sua função ou composição. Essa diversidade reflete a multiplicidade de microrganismos e as diferentes finalidades para as quais são cultivados.
Meios Líquidos (Caldos): São utilizados para o crescimento de microrganismos em suspensão. São ideais para obter grandes quantidades de biomassa microbiana, para testes de fermentação (observando a produção de gás ou alterações de pH), e para o enriquecimento inicial de amostras onde o microrganismo de interesse pode estar presente em pequeno número. Exemplos incluem o Caldo Nutriente e o Caldo Tripticase Soja (TSB).
Meios Sólidos: Contêm um agente solidificante, geralmente ágar (1,5-2,0%), e são preparados em placas de Petri, tubos inclinados (slants) ou tubos profundos (deeps). Permitem o isolamento de colônias puras, a contagem de microrganismos (Unidades Formadoras de Colônia - UFC), a observação da morfologia colonial e a realização de testes de sensibilidade a antimicrobianos. O Ágar Nutriente é um exemplo básico.
Meios Semissólidos: Contêm uma menor concentração de ágar (geralmente 0,3-0,5%), resultando em uma consistência gelatinosa. São frequentemente utilizados para determinar a motilidade bacteriana (observando o crescimento difuso a partir do ponto de inoculação) e para promover o crescimento de microrganismos microaerófilos (que requerem baixas concentrações de oxigênio).
Além da consistência, os meios são classificados funcionalmente:
-
Meios Simples ou Basais: Fornecem os nutrientes básicos para o crescimento de microrganismos não fastidiosos. O Ágar Nutriente e o Caldo Nutriente são exemplos clássicos.
-
Meios Enriquecidos: São meios basais aos quais foram adicionados nutrientes suplementares, como sangue, soro, extrato de levedura ou vitaminas, para permitir o crescimento de microrganismos fastidiosos, que possuem exigências nutricionais complexas. O Ágar Sangue, que consiste em um meio base (como Ágar Tripticase Soja) com adição de 5-10% de sangue de carneiro desfibrinado, é um exemplo proeminente, permitindo não apenas o crescimento de muitos patógenos, mas também a observação de reações de hemólise (alfa, beta ou gama), que auxiliam na identificação bacteriana, como no caso de espécies de Streptococcus.
-
Meios Seletivos: São formulados para favorecer o crescimento de determinados microrganismos enquanto inibem o crescimento de outros presentes na mesma amostra. Essa seletividade é alcançada pela adição de substâncias inibitórias, como antibióticos, sais biliares, corantes ou ajuste extremo de pH. O Ágar MacConkey é um exemplo clássico de meio seletivo e diferencial. Ele contém sais biliares e cristal violeta, que inibem o crescimento da maioria das bactérias Gram-positivas, selecionando assim as Gram-negativas, especialmente enterobactérias. Outro exemplo é o Ágar Manitol Salgado (MSA), que possui alta concentração de cloreto de sódio (7,5%), inibindo a maioria das bactérias, exceto estafilococos, e também é diferencial para Staphylococcus aureus.
-
Meios Diferenciais (ou Indicadores): Permitem distinguir diferentes tipos de microrganismos cultivados no mesmo meio com base em suas características bioquímicas. Contêm indicadores (como corantes de pH ou substratos específicos) que mudam de aparência (cor, precipitação) em resposta a reações metabólicas específicas de certos microrganismos. O Ágar MacConkey, além de seletivo, é diferencial porque contém lactose e o indicador vermelho neutro. Bactérias fermentadoras de lactose produzem ácido, baixando o pH e fazendo com que as colônias apareçam rosadas ou vermelhas, enquanto as não fermentadoras permanecem incolores. O Ágar Sangue também é diferencial, pois permite a visualização dos diferentes tipos de hemólise. O Ágar Eosina Azul de Metileno (EMB) é seletivo para Gram-negativas e diferencial para fermentadores de lactose, com Escherichia coli tipicamente produzindo um brilho verde metálico característico.
-
Meios de Transporte: São utilizados para manter a viabilidade de microrganismos em amostras clínicas durante o transporte do local de coleta até o laboratório, prevenindo o ressecamento e o supercrescimento de contaminantes, sem permitir a multiplicação significativa do patógeno. Exemplos incluem o meio de Stuart e o meio de Amies.
-
Meios para Contagem: São formulados para permitir a enumeração de microrganismos em amostras, como o Ágar Padrão para Contagem (PCA), utilizado na análise de alimentos e água.
-
Meios Cromogênicos: Representam uma inovação mais recente e são um tipo especializado de meio diferencial. Contêm substratos cromogênicos que, quando clivados por enzimas específicas produzidas por determinados microrganismos, liberam cromóforos (moléculas coloridas), resultando em colônias com cores distintas e facilitando a identificação direta e rápida. São amplamente utilizados em microbiologia clínica e de alimentos para a detecção de patógenos específicos, como Salmonella spp., Listeria monocytogenes e Candida albicans.
A utilização desses diversos meios é vasta. Na microbiologia clínica, são essenciais para o diagnóstico de doenças infecciosas, isolando e identificando o agente etiológico e realizando testes de suscetibilidade a antimicrobianos para guiar a terapia. Na indústria alimentícia e farmacêutica, são cruciais para o controle de qualidade, monitorando a contaminação microbiana em matérias-primas, processos e produtos finais, além de serem usados na produção de alimentos fermentados (iogurte, queijo, cerveja) e produtos farmacêuticos (antibióticos, vacinas, enzimas). Em pesquisa, os meios de cultura são a base para estudos de fisiologia, genética, ecologia e evolução microbiana. Na biotecnologia, são empregados para o cultivo de microrganismos geneticamente modificados para a produção de proteínas recombinantes, biocombustíveis e outros bioprodutos.
Considerações Finais e Perspectivas Futuras
A trajetória dos meios de cultura, desde os caldos simples de Pasteur até os modernos meios cromogênicos e formulações especializadas, ilustra um campo em constante evolução, impulsionado pela necessidade de ferramentas mais rápidas, precisas e eficientes para o estudo e manipulação de microrganismos. A capacidade de cultivar microrganismos em laboratório permanece como uma das técnicas mais fundamentais e poderosas da microbiologia, sustentando avanços em medicina, indústria, agricultura e pesquisa básica.
As inovações continuam, com o desenvolvimento de meios que incorporam biossensores, nanotecnologia e técnicas de automação para detecção e identificação microbiana ainda mais rápidas. A integração com métodos moleculares, como a Reação em Cadeia da Polimerase (PCR) e o sequenciamento de nova geração (NGS), não substitui a cultura, mas muitas vezes a complementa, especialmente quando microrganismos viáveis são necessários para estudos fenotípicos, testes de suscetibilidade ou produção. A busca por meios mais sustentáveis, com componentes de fontes renováveis e menor impacto ambiental, também é uma tendência crescente.
Em suma, os meios de cultura são muito mais do que simples “sopas nutritivas” para micróbios; são janelas para o mundo microscópico, permitindo-nos desvendar seus mistérios, aproveitar seus benefícios e mitigar seus riscos. A contínua pesquisa e desenvolvimento nesta área são cruciais para enfrentar os desafios futuros, desde o surgimento de novas doenças infecciosas e a resistência antimicrobiana até a necessidade de processos biotecnológicos mais eficientes e sustentáveis. A história dos meios de cultura é uma prova da engenhosidade científica e de sua capacidade de transformar nossa interação com o mundo vivo.
Referências